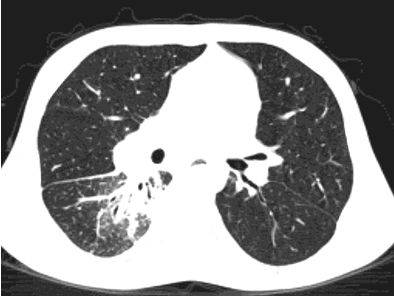
Расшифровка кт органов грудной клетки

Причины возникновения очаговых образований в легких
К основным факторам патологии относят возникновение уплотнений на легких. Такие симптомы присущи опасным состояниям, которые при отсутствии правильной терапии могут вызвать летальный исход. К болезням, которые спровоцировали это состояние, относят:
Причиной возникновения очага является очаговый туберкулез
- онкологические заболевания, последствия их развития (метастазы, непосредственно новообразования и пр.);
- очаговый туберкулез;
- воспаление легких;
- отеки, вызванные нарушением кровообращения или как вследствие аллергической реакции;
- инфаркт миокарда;
- кровотечения;
- сильные ушибы грудной клетки;
Чаще всего уплотнения возникают из-за воспалительных процессов (острой пневмонии, туберкулеза легких) или онкозаболеваний.
У трети пациентов наблюдаются незначительные признаки поражения органов дыхания. Особенностью туберкулеза легких является отсутствие симптомов или минимальное их проявление. В основном его выявляют при профилактических осмотрах. Основную картину туберкулеза дает рентгенография легких, но она имеет различие в зависимости от фазы и продолжительности процесса.
https://youtube.com/watch?v=qfmxm7k5suM
Врачи отмечают, что очаги на КТ легких могут свидетельствовать о различных заболеваниях, от инфекций до онкологических процессов. При интерпретации результатов важно учитывать клиническую картину пациента, его анамнез и сопутствующие симптомы. Специалисты подчеркивают, что наличие очагов требует дальнейшего обследования, включая дополнительные визуализационные методы и, возможно, биопсию. Важно также помнить, что не все очаги являются злокачественными; некоторые из них могут быть доброкачественными образованиями или следствием воспалительных процессов. Поэтому комплексный подход к диагностике и индивидуальный анализ каждого случая являются ключевыми для правильного определения диагноза и выбора оптимальной тактики лечения.

Как очаги в легких выглядят на снимке КТ?
Чтобы человек несведущий смог разобраться в результатах КТ, следует знать о нюансах чтения снимков. Рассмотрим самые актуальные:
- Очаговые образования представляют собой участки белого цвета на черном фоне (на снимке-негативе). В реальности пораженная область, скорее всего, имеет более темный цвет, чем здоровые ткани легкого.
- Если врач заметит на снимке участки кальцинирования или обызвествления (капсул, пропитанных солями кальция) вокруг очага, это может быть признаком доброкачественности образования. Кальцинаты по цвету похожи на кости скелета, видимые на этом снимке. Такие явления часто обнаруживаются после затяжных простудных заболеваний, бронхитов или уже излечененного туберкулеза и представляют собой некий шрам на легких. Пациента с образованием, на котором заметны признаки кальцината, пульмонологи обычно просят раз в полгода делать контрольные снимки.
- В случае, когда образование представляет собой так называемое «облачко» или очаг по типу «матового стекла», требуется более предметное обследование. Внешне оно выглядит как затуманенная область с размытыми границами. В ряде стран пациентам с такими образованиями сразу рекомендуется операция, даже если оно не растет. Уже доказано, что в 80% случаев такие очаги являются предраковым состоянием легких. Альтернатива немедленной операции — постоянное наблюдение с контрольными снимками раз в полгода-год.
В заключение отметим, что не стоит паниковать, если на снимке обнаружены изменения в легких в виде очагов. Чаще эти явления оказываются фиброзными образованиями, не требующими лечения. Однако стоит непременно пройти полное обследование и проконсультироваться с пульмонологом, чтобы исключить более серьезные болезни.
Пневмофиброз легких – что это
В настоящее время пневмофиброз встречается, к сожалению, все чаще. Объясняется это тем, что:
- Постоянно возрастает влияние вредных веществ на легкие. Воздух, которым мы дышим, с каждым днем становится все грязнее и медленно разрушает легочную ткань.
- Увеличивается частота хронизации патологических процессов в легочной ткани, которые неуклонно ведут к развитию пневмофиброза. Основа пневмофиброза – это постепенное изменение эластичности легких, ухудшение процессов газообмена.
Вытеснение соединительной тканью легочной ткани происходит постепенно. В целом, динамику такого процесса можно охарактеризовать несколькими этапами развития:
- Прогрессирующая гипоксия в легких. Недостаток кислорода активизирует фибробласты – клетки соединительной ткани, которые при гипоксии начинают активно продуцировать коллаген. Именно этот, постоянно образующийся, коллаген и представляет собой ту соединительную ткань, которая замещает легочную.
- Нарушение вентиляции легких. При нормальных физиологических условиях ткань легких эластичная и активно участвует в процессе дыхания. При повышении эластичности легочной ткани организму становится сложнее растягивать ее, чтобы совершать полноценные дыхательные движения. В таких условиях давление внутри легких начинает повышаться, стенки альвеол сдавливаются.
В норме альвеола при вдохе должна расправляться, но так как пневмофиброз постепенно охватывает легкое, многие альвеолы уже не могут выполнять своих функций, так как поражены соединительной тканью. В свою очередь, соединительная ткань не обладает достаточными эластичными свойствами и альвеолы, которые теряют свою эластичность, перестают участвовать в дыхательных движениях.
Это происходит потому, что слабым альвеолам практически не нужно усилий для растяжения, давление в них понижается и они просто начинают спадаться. Такие участки исключаются из процесса дыхания, в них не попадает кислород, функциональная поверхность легких уменьшается.
- Нарушение дренажных функций. Воспаление стенки бронхов приводит к ее отеку. Способность к оттоку воспалительного секрета (экссудата) значительно снижается и происходит его накопление. На фоне постоянного скапливания воспалительной жидкости происходит развиваются благоприятные условия для возникновения инфекции, которая приведет к воспалению всех остальных участков легкого.
Бронхи при этом начинают закупориваться, внутрилегочное давление меняется и доля или участок легкого с такими пораженными бронхами начинает спадаться, не принимая участия в совершении дыхательных движений.
- Нарушение лимфо- и кровообращения. Рост соединительной ткани приводит к сдавлению легочных сосудов. В таких артериях и венах начинают развиваться застойные явления. В случае длительности такого положения застойная жидкость начинает пропотевать сосудистые стенки, образуя участки выпота. Такие участки, не находя выхода, начинают также замещаться соединительной тканью, еще более ухудшая состояние легких.
Справочно. Итогом таких нарушений становится дыхательная недостаточность.
Очаги на КТ легких вызывают множество обсуждений среди врачей и пациентов. Многие пациенты испытывают тревогу при получении такого заключения, так как это может указывать на различные заболевания, от инфекций до опухолей. Врачам важно объяснять, что наличие очагов не всегда означает серьезную патологию. Часто такие изменения могут быть связаны с воспалительными процессами или даже с предыдущими инфекциями, такими как пневмония.
Специалисты подчеркивают, что для точной диагностики необходимо учитывать клиническую картину, историю болезни и результаты дополнительных исследований. Важно не паниковать, а обратиться за консультацией к врачу, который сможет объяснить результаты КТ и предложить дальнейшие шаги. Таким образом, осведомленность и спокойствие играют ключевую роль в восприятии информации о состоянии легких.

Категории
АллергологАнестезиолог-реаниматологВенерологГастроэнтерологГематологГенетикГинекологГомеопатДерматологДетский гинекологДетский неврологДетский урологДетский хирургДетский эндокринологДиетологИммунологИнфекционистКардиологКосметологЛогопедЛорМаммологМедицинский юристНаркологНевропатологНейрохирургНефрологНутрициологОнкологОнкоурологОртопед-травматологОфтальмологПедиатрПластический хирургПроктологПсихиатрПсихологПульмонологРевматологРентгенологСексолог-АндрологСтоматологТерапевтУрологФармацевтФитотерапевтФлебологХирургЭндокринолог
11 ответов
Не забывайте оценивать ответы врачей, помогите нам улучшить их, задавая дополнительные вопросы по теме этого вопроса.Также не забывайте благодарить врачей.
Кудря Елена Александровнапульмонолог 2017-08-09 19:45
Здравствуйте, Альфия69,! Начну отвечать по порядку. Из-за этого гемоглобин понизится не может. (какой?). Есть бронхоэктатическая болезнь, этому заболеванию всегда предшествует ХОБЛ. Вы не указали хрпонические заболевания. Был ли выявлен ХОБЛ? какие показатели спирографии? Какие сопутствующие заболевания? Что из медикаментов принимаете?
Альфия69 2017-08-10 08:35
Спасибо за ответ. Я всю жизнь кашляю, много раз в детстве были пневмонии, всегда считала что у меня хронический бронхит. ХОБЛ никогда мне не ставили. Я принимала лоратадин от аллергии, и выпила большое количество ибупрофена вместе с аспирином, т. к весной и в начале постоянно простывала. И сейчас очень быстро простываю, чуть ветерок и кашель. Посоветуйте мне лечение. Я кашляю от переживаний, если наклоняюсь. Вчера делала ФГДС мне побрызгали ледокоин потом вечером не могу дышать лежа пришлось брызнуть сальбутомол.
Увеличить
Кудря Елена Александровнапульмонолог 2017-08-10 09:22
Спирограмма, вижу, делалась с фармакопробой с беродуалом. Цифры не вижу, также не вижу заключения, должнобыть написано: проба положительная (или отрицательная), прирост ОФВ1 столько-то процентов. В зависимости от этих процентов и ориентируемся в диагнозе. А как помогает сальбутамол? Сколько пользуетесь? На что аллергия?
Альфия69 2017-08-10 09:48
В спирограмме заключения нет. Но врач который делала сказала что без изменений. Сальбутамол помогает хорошо, но боюсь им пользоваться чтоб не привыкнуть. Я им пользовалась сегодня только второй раз. Первый раз я почистила горячую духовку уксусом на следующий день начался кашель как собака лает, дышала как собака особенно тяжело было когда ложилась, сальбутамол помог. Аллергия на запахи. Скажите пожалуйста почему бывает кровь и алая и ее много
Кудря Елена Александровнапульмонолог 2017-08-10 12:43
Если сальбутамол помогает. Пользуйтесь ним. Привыкания ни к каким ингаляторам нет, это миф. Просто мы советуем пользоваться сальбутамолом не больше 4 раз в день для предупреждения побочных эффектов. Но если человек пользуется сальбутамолом больше 2 раз в день надо переходить на лечебные ингаляторы (сальбутамол не лечит, он просто купирует спазм). Это может быть кашлевая форма бронхиальной астмы. Кровь — это сосудики надрываются от перенапряжения при кашле, долго — из-за анемии. А вот причину анемии надо поискать.
Альфия69 2017-08-10 12:51
Спасибо за ответ
Альфия69 2017-08-10 12:55
Посмотрите пожалуйста мои анализы
Увеличить
Альфия69 2017-08-10 12:56
Увеличить
Альфия69 2017-08-10 12:56
Увеличить
Альфия69 2017-08-10 12:57
А это анализы прошлого года
Увеличить
Кудря Елена Александровнапульмонолог 2017-08-10 14:03
Как-то вы фотографируете, что при всем увеличении я цифр и букв не вижу. Кроме того, любые анализы максимум учитываются 10 дней.
Лечение пневмофиброза
По завершении проведения всех необходимых диагностических манипуляций необходимо начинать лечение.
Важно, что для пневмофиброза легких лечение должно быть только комплексным с применением всех указанных терапевтических мероприятий. Основными лечебными мероприятиями, направленными на улучшение состояния здоровья пациентов, являются:
Основными лечебными мероприятиями, направленными на улучшение состояния здоровья пациентов, являются:
- Лечение основного заболевания, которое послужило причиной развития пневмофиброза.
- Применение антибактериальных лекарственных препаратов широкого спектра действия при признаках инфекционного поражения (выбор антибиотиков зависит только от состояния больного и его сопутствующих патологий.
- Назначение отхаркивающих препаратов на химической и растительной основе (АЦЦ, Лазолван, Бромгексин, корень солодки, анис, розмарин).
- Прием глюкокортикостероидов для усиления противовоспалительной терапии (Преднизолон, Дексаметазон).
- Сердечные гликозиды при сопутствующей сердечной недостаточности (Коргликон, Строфантин).
- Витаминотерапия.
- Физиотерапевтические методы лечения в зависимости от состояния и показаний.
- Терапия кислородом.
- Дыхательная гимнастика.
- Диета.
К сожалению, полное излечение от пневмофиброза в настоящее время невозможно. Цель лечения – это остановить патологический процесс, максимально сохранить показатели активности дыхательных функций и отсрочить развитие дыхательной недостаточности.
Справочно. Запущенные формы являются показанием к хирургическому лечению.
Более того, не нужно надеяться на то, что пневмофиброз можно вылечить дома, в домашних условиях. Таким подходом можно только ухудшить течение заболевания и его прогноз.
Внимание! Лечение пневмофиброза проводится только в условиях стационара!
Все пациенты с подтвержденным диагнозом пневмофиброза должны не менее года состоять на диспансерном учете.
КТ легких: показания
Томографию легких для первичной постановки диагноза назначают, если у пациента наблюдается:
- длительный кашель, в том числе с кровью и нетипичным отделяемым;
- непрекращающаяся лихорадка, постоянно повышенная температура тела;
- головные, мышечные боли невыясненного происхождения;
- синюшность губ, кожных покровов;
- общая слабость, быстрая утомляемость;
- боли в груди ноющего и острого характера.
Велика диагностическая ценность КТ при оценке эффективности противоопухолевой терапии. Практически моментальное получение результатов обследования позволяет быстро скорректировать тактику лечения.
В каком случае еще назначают КТ легких? Диагностика может быть показана при травмах грудной области, в том числе сопровождающихся пневмотораксом (разрывом легочной ткани), кровотечениями, при выявлении на рентгенографии патологических очагов, свидетельствующих о пневмонии, эмфиземе, абсцессах, при увеличении внутригрудных лимфоузлов.
Стоит заметить, что назначение на КТ выдает лечащий врач. Он же указывает на необходимость использования контраста и ставит окончательный диагноз.
Суть исследования
Томография является высокоинформативным методом послойного исследования тканей и внутренних органов, позволяющим увидеть на снимке даже самые мелкие детали – хорошо визуализируются очаги размером в 1–2 мм. Она относится к рентгенологическим исследованиям, когда изображение формируется путем просвечивания каждого среза, толщина и направление которого может регулироваться, исходя из характера легочной патологии.
Проходя сквозь ткани различной плотности, излучение ослабевает, а степень его изменения регистрируется чувствительными сенсорами. Полученная информация анализируется компьютером и нередко представляется в виде трехмерной картинки. Томографическое исследование легких может выполняться в нескольких режимах:
- Непрерывный – делают все срезы органа.
- Дискретная – интервал между срезами увеличен.
- Прицельная – анализируют лишь определенный участок органа.
Сравнивая КТ легких при пневмонии с обычным рентгенологическим исследованием, преимущества томографии очевидны: более высокая чувствительность и точность. Она позволяет обнаружить наиболее мелкие детали патологического процесса, не давая усомниться в диагнозе. Однако исследование не так доступно и сопряжено с более существенной лучевой нагрузкой на пациента.
Почему возникают и чем опасны очаги в легких
Очаговые образования в легких — уплотнение ткани, вызываемое различными заболеваниями. Обычно они выявляются в результате рентгенологического исследования. Иногда осмотра специалиста и методов диагностики бывает недостаточно, чтобы сделать точное заключение. Для окончательного подтверждения нужно провести специальные методы обследования: анализы крови, мокрот, пункцию тканей. Происходит это при злокачественных опухолях, пневмонии и нарушении обмена жидкости в дыхательной системе.
- Что такое очаги в легких?
- Причины возникновения очаговых образований в легких
- Основные способы диагностики
- Разновидности очаговых образований
- Заключение
Существует определенная разница между международно установленным понятием очаговых образований, и тем, что принято в отечественной медицине. За рубежом к ним относят уплотнения в легких размером около 3 см. Отечественная медицина ставит ограничения до 1 см, а другие образования относит к инфильтратам.
Компьютерная томография способна с большей вероятностью установить размер, форму уплотнения легочной ткани. Это исследование тоже обладает процентом погрешности.
Очаговые образования в органах дыхания представлены в качестве дегенеративных изменений в тканях легких или скапливании жидкости в виде мокроты или крови. Многие специалисты считают одной из важных задач их установление.
До 70% одиночных очагов в легких относятся к злокачественным новообразованиям. С помощью КТ (компьютерной томографии), и базируясь на специфических симптомах, специалист может предположить о возникновении таких опасных патологий, как туберкулез или рак легких.
Однако для подтверждения диагноза требуется сдать необходимые анализы. Аппаратного обследования для получения медицинского заключения в некоторых случаях недостаточно. У современной медицины не существует единого алгоритма для проведения исследований при всех возможных ситуациях. Специалист рассматривает каждый случай отдельно.
Провести аппаратным методом четкую диагностику заболевания не позволяет несовершенство оборудования. При прохождении рентгенографии легких трудно обнаружить очаговые изменения, размер которых не достигает 1 см. Интерпозиция анатомических структур делает невидимыми и более крупные образования.
Специалист предлагает больным пройти обследование с помощью компьютерной томографии. Она позволяет рассмотреть ткани под любым углом.
Показания
Известно, что пневмония устанавливается на основании клинико-рентгенологических признаков. Если же обычного снимка становится недостаточно (он малоинформативен или сомнителен), то выполняют КТ. Исследование прежде всего выполняется в следующих ситуациях:
- Распознавание мелкоочаговых изменений.
- Обнаружение осложнений (абсцедирование, ателектаз, пиоторакс).
- Дифференциальная диагностика с другими заболеваниями (рак легких, туберкулез, пневмокониозы, саркоидоз).
Когда на рентгенограмме отсутствует динамика воспалительного процесса, заболевание приобретает затяжной характер и не реагирует на стандартную терапию, также рассматривается вопрос о назначении томографии. На КТ можно определить инфаркт-пневмонию, возникшую при тромбоэмболии легочной артерии. Кроме того, она позволяет выявить инфильтрацию на более ранних стадиях, что позволит сразу же начать соответствующее лечение.
Похожие и рекомендуемые вопросы
Подскажите как мне дальше быть? Помогите пожалуйста разобраться, устала когда отправляют…
Уточнение диагноза по КТ грудной клетки? Уважаемый Доктор! Мужу 58 лет. 21.08 2016г…
Затемнение в лёгком s8 Подскажите пожалуйста у меня такая проблема обнаружели затемнение…
Единичные очаги, неправильно-округлой формы, в легких Сделали плановую флюорографию,…
Единичные очаги в лёгком Жалоб у меня нет, но на обзорном рентгеновском снимке в среднелатеральном…
Результаты КТ расшифровка описания Сегодня получила результаты КТ, можете мне разъяснить…
Есть ли какое-то лечение? . На контрольной КТ, по сравнению с 2016,2017 г. , отмечается…
Сильный удушливый кашель Сегодня сделали РКТ органов грудной клетки(СИД-2.49м3в)….
Результ кт легких
Здравствуйте. Мне 50 лет. Я женщина. Рост 155, вес 86 кг. Получила…
Небольшая одышка, расшифровка КТ При лечение в стационаре по поводу ИБС, гипертонии…
Расшифровка КТ легких Я бы хотела получить расшифровку и консультацию КТ оргаонов…
Мскт картина единичных паравазальных участков уплотнения легочной ткани Наличие приступов…
Консультация по кт легких Проконсультируйте пожалуйста по поводу томографии.
Грудная…
Боль в правом боку и очаговые образования Я уже обращался с эти вопросом, просто уезжал…
Очаговое образование в S9 левого легкого Моей маме поставили диагноз по результатам…
Затемнения на флюорографии, что это может быть? У мужа на флюорографии обнаружить…
У мамы кашель, одышка, боль в боку, повышение температуры до 38 В 17.07.2012г моей…
Округлый фокус в S8 нижней доли правого легкого У жены кашель с отделением желтой…
Целесообразна ли операция при моем диагнозе или возможно альтернативное лечение? Евгений Федорович. В августе 2017 года я прошла флюорографию, которая показала затемнение во втором сегменте легкого. Осмотра в мае 2017. Прошла лечение от пневмонии, последующий снимок показал наличие этого же затемнения без изменения. Результат прохождения первого РКТ 10 октября 2017г.:
Средостение расположено в типичном месте, в размерах не увеличено, с четкими контурами, обычной формы, без очаговых патологических образований.
В паренхиме S1-S2 сегментов верхней доли правого легкого определяются гетерогенные интертисциальные изменения за счет полиморфных очагов, размером от 8,5 мм до 44,1 мм в поперечнике, на фоне которых визуализируются участки уплотнения по типу матового стекла
В других сегментах паренхима без очаговых патологических образований, нормальной пневматизации. Архитектоника легочного и сосудистого рисунка легких без особенностей. Просвет трахеи и главных бронхов свободен, стенки без патологических изменений. Легочные синусы свободные, без патологических изменений. Легочные синусы свободные, без патологических изменений. Плевральные листки не утолщены.
Лимфоузлы переднего средостения (стернальные, преваскулярные и прекардиальные) не визуализируются. Лимфоузлы заднего средостения не увеличины. Лимфоузлы центрального средостения не увеличены.
Повторное РКТ 9 января 2018г. дало тот же результат, единственная разница в размерах: в первом случае от 8,5мм до 44,1мм. В поперечнике, во втором случае от9,6 мм до 44.4 мм в поперечнике.
Результат биопсии легкого от 17 октября: Опухолевидный стеноз В2верхнедолевого бронха справа III степени(полный) за счет обтурации просвета (с распадом).
Результат биопсии от 20 октября 2017 года: Уплотнение верхней доли правого легкого (ателектаз).
Опухолевидный стеноз (В2) верхнедолевого бронха справа III степени за счет обтурации просвета сдавления извне и инфильтрации слизистой оболочки (с распадом).
Результаты онкомаркеров отрицательные.
Заранее благодарна за понимание
Не улучшается состояние после лечения пневмонии Меня зовут Аня, 21 год. В начале сентября…
Компьютерная томография ОГК позволяет диагностировать многие заболевания. По ее результатам специалист сможет:
- поставить уточненный диагноз;
- определить локализацию процесса, его стадию;
- назначить эффективное лечение;
- контролировать динамику терапии, назначив повторную томографию;
- оценить состояние легких, плотности тканей, внешний вид альвеол, измерить дыхательный объем;
- рассмотреть большинство легочных сосудов, легочную артерию, верхнюю полую вену, трахею, бронхи, лимфатические узлы.
Чтобы человек несведущий смог разобраться в результатах КТ, следует знать о нюансах чтения снимков. Рассмотрим самые актуальные:
- Очаговые образования представляют собой участки белого цвета на черном фоне (на снимке-негативе). В реальности пораженная область, скорее всего, имеет более темный цвет, чем здоровые ткани легкого.
- Если врач заметит на снимке участки кальцинирования или обызвествления (капсул, пропитанных солями кальция) вокруг очага, это может быть признаком доброкачественности образования. Кальцинаты по цвету похожи на кости скелета, видимые на этом снимке. Такие явления часто обнаруживаются после затяжных простудных заболеваний, бронхитов или уже излечененного туберкулеза и представляют собой некий шрам на легких. Пациента с образованием, на котором заметны признаки кальцината, пульмонологи обычно просят раз в полгода делать контрольные снимки.
- В случае, когда образование представляет собой так называемое «облачко» или очаг по типу «матового стекла», требуется более предметное обследование. Внешне оно выглядит как затуманенная область с размытыми границами. В ряде стран пациентам с такими образованиями сразу рекомендуется операция, даже если оно не растет. Уже доказано, что в 80% случаев такие очаги являются предраковым состоянием легких. Альтернатива немедленной операции — постоянное наблюдение с контрольными снимками раз в полгода-год.
Очаговые изменения
Очаговые изменения в лёгких могут быть разного размера. Очаги мелкого диаметра 1-10 мм выявляются при различных диффузных патологиях лёгочной ткани. Очаги с высокой плотностью и довольно чётки краями в основном наблюдаются в интерстиции лёгкого. Различные очаги низкой плотности, напоминающие матовое стекло, с нечёткими контурами возникают при патологических изменениях в респираторных отделах дыхательных органов.
Нужно учитывать, что плотность и размер очагов имеет слабое диагностическое значение. Для постановки диагноза более важным может быть распределение патологических процессов в лёгочной ткани:
- Перилимфатический очаг – часто наблюдается в бронхах, сосудах, в междольковых перегородках и листках плевры. В таком случае видны неровные контуры анатомических структур, при этом перегородочки и стенки бронхов несколько утолщены, как и стенки сосудов. Подобные патологические изменения часто встречаются при туберкулёзе, силикозе, саркоидозе и карциноматозе. При этих патологиях очаги небольшие и не превышают 2-5 мм. Состоят такие очаги из гранулем или метастатических узелочков, они наблюдаются вдоль лимфатических узелков в ткани лёгких и плевре.
- Полиморфный очаг. Такие очаговые образования в ткани лёгких возникают при туберкулёзе. В этом случае КТ позволяет увидеть участки разной плотности и размеров. В некоторых случаях такая картина наблюдается при онкологических патологиях.
- Центрилобулярные очаги. Наблюдаются в артериях и бронхах или в непосредственной близости от них. Они могут быть довольно плотными, хорошо очерченными и однородными. Изменения лёгочной ткани такого типа наблюдаются при пневмониях, эндобронхиальном туберкулёзе и разных видах бронхита, преимущественно бактериального происхождения. Есть и другой тип центрилобулярных очагов, в этом случае лёгочная ткань имеет мелкие уплотнения и похожа на матовое стекло.
- Периваскулярные очаги – это патологические образования, которые находятся в непосредственной близости от кровеносных сосудов. Такое состояние наблюдается при онкологических патологиях и туберкулёзе. Очаги могут быть как единичные, так и множественные.
- Хаотично расположенные очаги. Такие образования характерны для патологических гематогенных процессов. Это может быть гематогенная инфекция, туберкулёз или метастазы гематогенного типа. Большие множественные очаги, размером около 10 мм, частенько наблюдаются при септических эмболиях, гранулематозе, грибковых инфекциях и метастазах. Все эти заболевания имеют некоторые отличия, по которым их можно дифференцировать.
- Субплевральные очаги – это патологически изменённые участки, расположенные под плеврой. Наблюдение таких участков на снимке всегда говорит о развитии туберкулёза или онкологических заболеваний.
- Плевральные очаги. Такие патологические образования расположены на плевре. Наблюдаются при воспалительных и инфекционных патологиях нижних дыхательных органов.
- Апикальный очаг представляет собой чрезмерное разрастание фиброзной ткани, которая со временем замещает здоровые клеточки.
- Лимфогенный карциноматоз. Это понятие включает два типа патологических изменений в лёгких. С правой стороны наблюдается альвеолярная инфильтрация, с видимыми просветами бронхов. С левой стороны плотность лёгочной ткани несколько повышена. В зоне уплотнения наблюдаются стенки бронхов и сосудиков.
При очаговых заболеваниях участки патологически изменённой ткани могут быть разными по размерам. Они могут быть мелкими, размером не более 2 мм, средними – диаметром до 5 мм и крупными, размер последних превышает 10 мм.
Патологические очаги бывают плотными, средней плотности, а также рыхлыми. Если в лёгких наблюдаются единичные уплотнения, то это может быть как возрастным изменением, которое не представляет опасности для человека, так и опасным заболеванием. Если наблюдаются множественные очаги, то здесь речь идёт о воспалении лёгких, туберкулёзе или редких формах онкологических заболеваний.
При попадании в лёгкие микобактерий туберкулёза развивается первичный очаг, который на снимке очень напоминает пневмонию. Однако отличие в том, что воспалительный процесс может длиться очень долго, иногда даже годами.
Вопрос-ответ
Что значит очаги в легких?
Единичный очаг – это локальный участок уплотнения легочной паренхимы, который на снимке отражается, как тень округлой или близкой к ней форме. По международным нормам – очагом можно считать образование до 3 см диаметров. По отечественным меркам – до 1 см.
Чем опасны очаги в легких?
Кальцинаты в легких сами по себе, в большинстве случаев, не опасны: единичные и небольшие кальцинаты не влияют на качество жизни, а крупные почти никогда не перерождаются в рак. Тем не менее, новообразования рекомендуется некоторое время наблюдать.
Что означают очаговые изменения в легких?
Доброкачественные очаговые образования легких — совокупность заболеваний легких, выявляющихся во время флюорографического или рентгенологического исследований в виде округлых теней, как правило, с четкими контурами. Выявляются в большей степени у лиц молодого и среднего возраста.
Как выглядят метастазы в легком на КТ?
Метастазы в легких на КТ Лимфогенные метастазы легких на КТ выглядят как множественные мелкие диссеминированные очаги. Они расположены вдоль междольковых перегородок и плевры. Картина напоминает туберкулез и саркоидоз, и в этой связи часто требует уточнения.
Советы
СОВЕТ №1
Обратите внимание на симптомы. Если у вас есть кашель, одышка, или другие респираторные симптомы, не откладывайте визит к врачу. Раннее обращение поможет быстрее выявить причину и начать лечение.
СОВЕТ №2
Регулярно проходите медицинские обследования. Компьютерная томография легких может выявить очаги на ранних стадиях, когда лечение наиболее эффективно. Обсудите с врачом, как часто вам следует проходить такие обследования.
СОВЕТ №3
Не игнорируйте результаты КТ. Если вам поставили диагноз, связанный с очагами в легких, обязательно следуйте рекомендациям врача и проходите все назначенные дополнительные исследования для точной диагностики и контроля состояния.
СОВЕТ №4
Обсуждайте результаты с врачом. Если у вас есть вопросы или сомнения по поводу полученных результатов КТ, не стесняйтесь задавать их своему врачу. Понимание состояния здоровья поможет вам принимать более обоснованные решения о лечении.